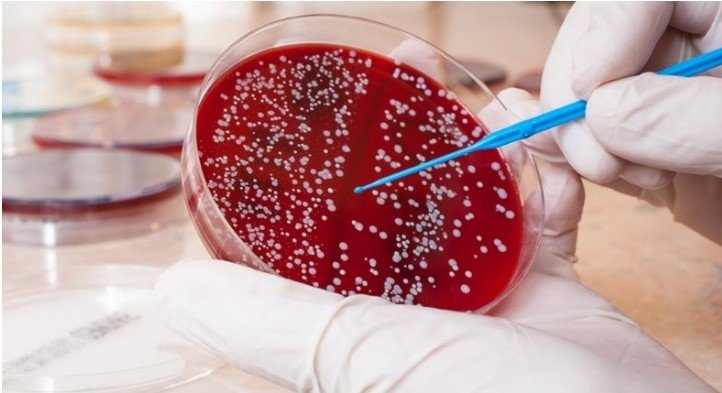

Xarkovda kişilər səfərbərliyə görə işə getməyə qorxur
Turkstan.az saytına istinadən Icma.az xəbər verir.
Nəşr, avtoservis sahibinin TsK-nın insanların işə çıxmağa qorxduğunu söylədiyi bir video yayımladı.
Turkustan.az xəbər verir ki, Xarkovda şəhər müəssisələrinə reydlər təşkil edən TTK-nın (ərazi çağırış mərkəzi, hərbi komissarlığın analoqu - TASS qeydi) məcburi səfərbərlik tədbirləri ilə əlaqədar olaraq, kişilərin əksəriyyəti işə getmir. Bu barədə “Strana” nəşri Xarkov avtomobillərinə texniki xidmət stansiyasının sahibinin dərc etdiyi videoya istinadən xəbər verir.
"Uzun müddət şəhərdəki vəziyyət haqqında heç nə demədim. Mən sadəcə restavrasiya üçün lamelləri götürməyə getdim, gördüm ki, lamelləri hazırladığımız oğlanlar yoxdur. Zəng etdim, dedilər ki, ətrafımızda hər yer bağlıdır, işə çıxmağa qorxuruq".
Bundan əvvəl xəbər verilmişdi ki, Xarkov vilayətinin hakimiyyət orqanları müdafiə qabiliyyətinin artırılması çərçivəsində regionda səfərbərlik fəaliyyətini gücləndirmək istəyir.
Qeyd edək ki, 2022-ci ilin fevralından Ukraynada ümumi səfərbərlik elan edilib və dəfələrlə uzadılıb, eyni zamanda hakimiyyət hərbi yaşda olan kişilərin xidmətdən yayınmasının qarşısını almaq üçün əlindən gələni edir. Bu il mayın 18-də ölkədə səfərbərliyin gücləndirilməsi haqqında qanun qüvvəyə minib və bu, daha yüz minlərlə ukraynalının ordu sıralarına cəlb olunmasına imkan verib.
Kişilər istənilən yolla - saxta sertifikatlardan istifadə etməklə və ya qeyri-qanuni yolla, çox vaxt həyatlarını riskə ataraq ölkəni tərk etməyə çalışırlar. Bundan əlavə, Ukrayna sosial şəbəkələrində mütəmadi olaraq hərbi komissarlıq əməkdaşlarının səfərbər edilmiş insanlara qarşı zor tətbiq edərək qanunları pozaraq videoları yayılır. Belə hadisələrin böyük əksəriyyəti cəzasız qalır.
Aytən Yaşar/ Turkustan.az
Yod çatışmazlığı bir yod şəbəkəsindən istifadə edərək müəyyən edilə bilər. Bu doğrudurmu?

Bayden gedənə yaxın səhvlərinin "möhürünü" vurdu - VİDEO

Avropa Birliyi ölkələri Netanyahunu həbs edəcəkmi?

Britaniyanın ən böyük bankı Rusiyadan ödənişləri qəbul etməyi dayandırdı

Azərbaycanda saxlanılan gömrük xidmətinin rəis müavini 200 milyon verib HƏBSDƏN ÇIXDI - FOTO

THY-dən yeni fürsət: sərnişinlər pulsuz şəhər turuna çıxacaqlar

Makronun bu addımı qalmaqala səbəb oldu

NATO-nun fövqəladə iclası: "Zelenski qorxuya düşdü"

Reuters Trampın Ukraynadakı mümkün elçisini açıqlayıb

ABŞ konqresmeni Baydeni İsrailə hərbi yardımı dayandırmağa çağırıb

Güney Azərbaycanda Turan bayrağı qaldırıldı

"Bizim tədarükümüz var, sınaqları davam etdirəcəyik" - Putin

Rəsmi Kreml səfərbərlik elan edib?

Rusiyanın ən yeni Oreşnik raketinin iş prinsipi təsvir edilmişdir

Ballistik raketdən istifadə: nüvə hücumu məşqi, yoxsa blef?

Təbrizdən İrəvana gedən azərbaycanlını döydülər

Zaxarova Zelenskini buna görə ələ saldı

Paşinyanın növbəti artistliyi: “Xalq üçün iş görürəm” şousu davam edir

SENSASİYA: Qərb Rusiya və Belarusa qarşı müharibəyə hazırlaşır
REKLAM SAHƏSİ
MANŞET XƏBƏRLƏRİ

70 kiloqram qızılla tutulan azərbaycanlı DİPLOMATDIR?

Zəngəzur dəhlizi bu tarixdə açıla bilər: Üç məsələdən biri həll olunur

Güney Azərbaycanda Turan bayrağı qaldırıldı

Qarabağa getmək istəyənlərin nəzərinə - Tarix açıqlandı

“Sülhlə bağlı Vaşinqtonun yanaşmasında dəyişikliklər gözlənilir” - DEPUTAT

Üçüncü Dünya müharibəsi rəsmən başladı?

"Xarkovda kişilər səfərbərliyə görə işə getməyə qorxur"

Azərbaycanda bəzi deputatlara mənzil VERİLDİ

Bayden gedənə yaxın səhvlərinin "möhürünü" vurdu - VİDEO

Avropa Birliyi ölkələri Netanyahunu həbs edəcəkmi?

Britaniyanın ən böyük bankı Rusiyadan ödənişləri qəbul etməyi dayandırdı

Azərbaycanda saxlanılan gömrük xidmətinin rəis müavini 200 milyon verib HƏBSDƏN ÇIXDI - FOTO

THY-dən yeni fürsət: sərnişinlər pulsuz şəhər turuna çıxacaqlar

Makronun bu addımı qalmaqala səbəb oldu

NATO-nun fövqəladə iclası: "Zelenski qorxuya düşdü"

70 kiloqram qızılla tutulan azərbaycanlı DİPLOMATDIR?

Reuters Trampın Ukraynadakı mümkün elçisini açıqlayıb

Zəngəzur dəhlizi bu tarixdə açıla bilər: Üç məsələdən biri həll olunur

ABŞ konqresmeni Baydeni İsrailə hərbi yardımı dayandırmağa çağırıb


Güney Azərbaycanda Turan bayrağı qaldırıldı

Bəzi məktəblərdə tədrisə START VERİLDİ

Mövlud Çavuşoğlu Azərbaycana GƏLİR

Biri 2600 manata... – Xaricdən “od qiyməti”nə alınan uzunqulaqlardan necə İSTİFADƏ OLUNACAQ?

"Bizim tədarükümüz var, sınaqları davam etdirəcəyik" - Putin

Rəsmi Kreml səfərbərlik elan edib?

Rusiyanın ən yeni Oreşnik raketinin iş prinsipi təsvir edilmişdir

Paşinyan: "İlin sonunadək Azərbaycanla sülh bağlamağa çalışacam"

Ballistik raketdən istifadə: nüvə hücumu məşqi, yoxsa blef?

Təbrizdən İrəvana gedən azərbaycanlını döydülər

Zaxarova Zelenskini buna görə ələ saldı

Paşinyanın növbəti artistliyi: “Xalq üçün iş görürəm” şousu davam edir

SENSASİYA: Qərb Rusiya və Belarusa qarşı müharibəyə hazırlaşır

Tükənmişlik sindromu nədir və müalicəsi necə aparılmalıdır?

Müəmmalı xəstəliyin gizli tərəfləri ÜZƏ ÇIXDI

İspaniya müharibədən qorunmaq üçün plan hazırlayır
Xərçəng əleyhinə unikal dərman uğurla sınaqdan keçirildi

Londonda bomba həyəcanı: ABŞ səfirliyi qarşısında "şübhəli paket"

Rusiyada yaşayan azərbaycanlıların nəzərinə: Bu gün son gündür

“Fransa məhz bu səbəbdən Bakıya gəlmədi” – VİDEO

Azərbaycanın COP29 Sədrliyi yekun bəyanat yaydı

Evdə hazırlanan turşuların saymaqla bitməyən faydaları

İran paytaxtını niyə dəyişmək istəyir? – Əsas səbəblər sırasında bunlar var


“Bakcell”in təşkilatçılığı ilə “Süni İntellektlə Dayanıqlılıq” mövzusunda panel müzakirəsi keçirildi

Avropa Netanyahunu necə həbs edə bilər? - Açıqlama

İrandan savaş qərarı: Bombardmançılar bölgəyə göndərildi

ChatGPT artıq kompüterlərdən də danışa biləcək

Paşinyan Araikin bunları açıqlamasını istəmir – Xaçatryan

İsraildən Beyruta intensiv bombardman

Avropa İttifaqı Meta-nı 797 milyon avro cərimələdi

Pezeşkian Azərbaycanla dəhlizin açılmasını İSTƏDİ

Bu meyvələrin qabığında da fayda var

Azərbaycan parlamentinin iclasları təxirə salınacaq - SƏBƏB

MEDİA jurnalistlər üçün müsabiqə elan etdi

Yazıb-oxumaq bilməyən Aşıq Ələsgər dühası

MEDİA-nın rəhbərliyi "Qarabağ" klubunun qonağı olub

"Baboşların, maboşların təbliğatı gedir" - DEPUTAT

Güllələnmiş atanın oğlu - Çingiz Aytmatovun şəcərəsi, ailəsi, sevdiyi qadınlar... - MARAQLI

Həm maaş, həm də pensiya alan deputatlar - SİYAHI

 Baxış sayı:121
Baxış sayı:121 Bu xəbər 23 Noyabr 2024 12:21 mənbədən arxivləşdirilmişdir
Bu xəbər 23 Noyabr 2024 12:21 mənbədən arxivləşdirilmişdir



 Daxil ol
Daxil ol
 Online Xəbərlər
Online Xəbərlər Xəbərlər
Xəbərlər Hava
Hava Maqnit qasırğaları
Maqnit qasırğaları Namaz təqvimi
Namaz təqvimi Kalori kalkulyatoru
Kalori kalkulyatoru Qiymətli metallar
Qiymətli metallar Valyuta konvertoru
Valyuta konvertoru Kredit Kalkulyatoru
Kredit Kalkulyatoru Kriptovalyuta
Kriptovalyuta Bürclər
Bürclər Sual - Cavab
Sual - Cavab İnternet sürətini yoxla
İnternet sürətini yoxla Azərbaycan Radiosu
Azərbaycan Radiosu Azərbaycan televiziyası
Azərbaycan televiziyası Haqqımızda
Haqqımızda Əlaqə
Əlaqə



 TDSMedia © 2026 Bütün hüquqlar qorunur
TDSMedia © 2026 Bütün hüquqlar qorunur








 Günün ən çox oxunanları
Günün ən çox oxunanları



















